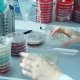
Krankenpflegefachkraft / Rettungssanitäter:in (m/w/d) VZ, Ulm - 6

Stellenangebot Krankenpfleger in Ulm, MVZ Urologieteam Ulm GmbH | Urologische Gemeinschaftspraxis
merken
vom 07.11.2025
Job-Informationen
- Anstellungsart:
- angestellt
- Anstellungsdauer:
- unbefristet
- Arbeitsumfang:
- Vollzeit
Unternehmen
Die MVZ Urologieteam Ulm GmbH ist eine urologische Gemeinschaftspraxis mit zwei Standorten in Ulm. Sie bietet ein breites Spektrum an Diagnostik, Therapie und Vorsorge im Bereich der Urologie. Besonderen Wert legt das Team auf eine individuelle, respektvolle Betreuung – mit einer ausdrücklich inklusiven Haltung gegenüber LGBTQIA+‑PatientInnen. Moderne Medizin, persönliche Zuwendung und ein diskriminierungsfreies Umfeld stehen im Mittelpunkt der Praxisphilosophie.
ausführliches FirmenprofilStellenbeschreibung
Zur Verstärkung unseres Teams suchen wir eine Krankenpflegefachkraft/ Rettungssanitäter:in (m/w/d) in Vollzeit in Ulm.
Arbeiten, wie es zu Ihnen passt – in einem Team, das Vielfalt lebt.
Wie sieht ein Arbeitsplatz aus, an dem Beruf und Leben im Gleichgewicht sind?
Bei uns im MVZ Urologieteam Ulm finden Sie genau das: ein Umfeld, das Freiraum lässt, Rückhalt bietet und den Menschen hinter der Aufgabe sieht.
Sprechen Sie mit uns - wir finden gemeinsam mit Ihnen ein Arbeitszeitmodell, das sich individuell an Ihre Lebenssituation anpasst. Ob früher Start, später Beginn oder individuelle Pausen, wir finden den Takt, der zu Ihrem Leben passt.
Zusätzliche Urlaubstage als Gesundheitsbonus schenken Erholung, wenn sie gebraucht wird, und das Homeoffice sorgt für mehr Ruhe an Tagen, die nach Konzentration verlangen.
Wir sorgen dafür, dass Ihr Arbeitsweg so angenehm wie möglich ist: Tankgutschein, Fahrtkostenzuschuss, Jobticket. Jobrad (wenn gewünscht) und ein eigener Parkplatz helfen Ihnen, entspannt anzukommen. Zusätzlich genießen Sie Prämien, vermögenswirksame Leistungen und weitere Benefits.
In unserem Team arbeiten Menschen mit unterschiedlichen Erfahrungen, Hintergründen, Identitäten und Altersgruppen – ob seit wenigen Jahren im Beruf oder 60+: Wir heißen alle willkommen – unabhängig von Geschlecht, sexueller Orientierung, Herkunft, Religion oder Alter. Diese Haltung prägt den Alltag in unserer Praxis und schafft ein respektvolles Umfeld, in dem sich jede Person wohl und sicher fühlt.
Ein attraktives Gehalt, Weiterbildungsangebote und die Wertschätzung eines Teams, das sich gegenseitig stärkt, runden das Bild ab.
Klingt nach dem richtigen Ort für Sie? Dann freuen wir uns darauf, Sie kennenzulernen!
Ihre Aufgaben:
- Betreuung und Vorbereitung unserer Patient*innen vor, während und nach urologischen Behandlungen
- Assistenz bei diagnostischen und therapeutischen Eingriffen
- Durchführung von Voruntersuchungen und Vorbereitung medizinischer Geräte
- Unterstützung bei organisatorischen Abläufen sowie Dokumentation und Terminmanagement
- Mitgestaltung eines strukturierten, wertschätzenden Arbeitsalltags im Team
Sie bringen mit:
- Eine abgeschlossene Ausbildung als Pflegefachkraft, Gesundheits- und Krankenpfleger*in, Rettungssanitäter:in oder vergleichbare Qualifikation
- Freude an der Arbeit im Praxisteam – bei uns zählt Vielfalt. Ob seit wenigen Jahren im Beruf oder 60+, wir schätzen unterschiedliche Perspektiven und Lebenswege
- Zuverlässige, einfühlsame und strukturierte Arbeitsweise
- Offenheit für neue Aufgaben, Interesse an Weiterqualifikationen sowie Wertschätzung von Teamarbeit und Einsatzbereitschaft
- Respektvoller Umgang mit allen Menschen ist für Sie selbstverständlich – im Kontakt mit Patient*innen ebenso wie mit Kolleg*innen
Wir bieten:
- Flexibles Arbeitszeitmodell
- Attraktives Gehalt
- 30 Tage Urlaub
- Zusätzliche Urlaubstage als Gesundheitsbonus
- Abwechslungsreicher Arbeitsplatz
- Weiterbildung für zusätzliche Qualifikationen
- Leistungsprämie
- Vermögenswirksame Leistungen
- Zusatzleistungen
- Brückentage frei
- Homeoffice
- Jobticket
- Firmenfahrrad/ Jobrad möglich
- Fahrtkostenzuschuss
- Kostenlose Dienstkleidung
- Parkplatz möglich
- Firmenevents
- Betriebsarzt
Wir freuen uns auf Ihre unkomplizierte Kontaktaufnahme - gerne per E-Mail oder telefonisch.
Ihr persönlicher Ansprechpartner ist Herr Dr. Löhmann.
Mitarbeiter Zusatzleistungen
Finanzielle Zusatzleistungen
- Jobticket
- Fahrtkostenzuschuss
- kostenlose Dienstkleidung
- vermögenswirksame Leistungen
- Firmenfahrrad
Work-Life-Balance
- Firmenevents
- Flexible Arbeitszeit
- Homeoffice
- Überdurchschnittlicher Urlaub
Sonstige Zusatzleistungen
- Betriebsarzt
- Parkplatz
- Weiterbildung
Eindrücke
Arbeitsort
MVZ Urologieteam Ulm GmbH | Urologische GemeinschaftspraxisBewerbung an
MVZ Urologieteam Ulm GmbH | Urologische Gemeinschaftspraxiskrankenpflegejobs24.de-b94363
(bitte in der Bewerbung angeben)